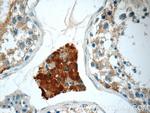
CHMP1A Antibody in Immunohistochemistry (Paraffin) (IHC (P))

Search
Proteintech
CHMP1A Polyclonal Antibody
{{$productOrderCtrl.translations['antibody.pdp.commerceCard.promotion.promotions']}}
{{$productOrderCtrl.translations['antibody.pdp.commerceCard.promotion.viewpromo']}}
{{$productOrderCtrl.translations['antibody.pdp.commerceCard.promotion.promocode']}}: {{promo.promoCode}} {{promo.promoTitle}} {{promo.promoDescription}}. {{$productOrderCtrl.translations['antibody.pdp.commerceCard.promotion.learnmore']}}
产品信息
15761-1-AP
种属反应
已发表种属
宿主/亚型
分类
类型
抗原
偶联物
形式
浓度
规格
纯化类型
保存液
内含物
保存条件
运输条件
产品详细信息
Immunogen sequence: MDDTLFQLK FTAKQLEKLA KKAEKDSKAE QAKVKKALLQ KNVECARVYA ENAIRKKNEG VNWLRMASRV DAVASKVQTA VTMKGVTKNM AQVTKALDKA LSTMDLQKVS SVMDRFEQQV QNLDVHTSVM EDSMSSATTL TTPQEQVDSL IMQIAEENGL EVLDQLSQLP EGASAVGESS VRSQEDQLSR RLAALRN (1-196 aa encoded by BC007527)
靶标信息
Probable peripherally associated component of the endosomal sorting required for transport complex III (ESCRT-III) which is involved in multivesicular bodies (MVBs) formation and sorting of endosomal cargo proteins into MVBs. MVBs contain intraluminal vesicles (ILVs) that are generated by invagination and scission from the limiting membrane of the endosome and mostly are delivered to lysosomes enabling degradation of membrane proteins, such as stimulated growth factor receptors, lysosomal enzymes and lipids. The MVB pathway appears to require the sequential function of ESCRT-O, -I, -II and -III complexes. ESCRT- III proteins mostly dissociate from the invaginating membrane before the ILV is released. The ESCRT machinery also functions in topologically equivalent membrane fission events, such as the terminal stages of cytokinesis and the budding of enveloped viruses (HIV-1 and other lentiviruses). ESCRT-III proteins are believed to mediate the necessary vesicle extrusion and/or membrane fission activities, possibly in conjunction with the AAA ATPase VPS4. Involved in cytokinesis. Involved in recruiting VPS4A and/or VPS4B to the midbody of dividing cells. May also be involved in chromosome condensation. Targets the Polycomb group (PcG) protein BMI1/PCGF4 to regions of condensed chromatin. May play a role in stable cell cycle progression and in PcG gene silencing.
仅用于科研。不用于诊断过程。未经明确授权不得转售。
生物信息学
蛋白别名: charged multivesicular body protein 1/chromatin modifying protein 1; Charged multivesicular body protein 1a; CHMP1; CHMP1a; chromatin modifying protein 1A; Chromatin-modifying protein 1a; hVps46-1; KIAA0047; procollagen (type III) N-endopeptidase; protease, metallo, 1, 33kD; unnamed protein product; Vacuolar protein sorting-associated protein 46-1; VPS46 homolog A; Vps46-1
基因别名: 2900018H07Rik; CHMP1; CHMP1A; KIAA0047; PCH8; PCOLN3; PRSM1; VPS46-1; VPS46A
UniProt ID: (Human) Q9HD42, (Mouse) Q921W0
Entrez Gene ID: (Human) 5119, (Mouse) 234852